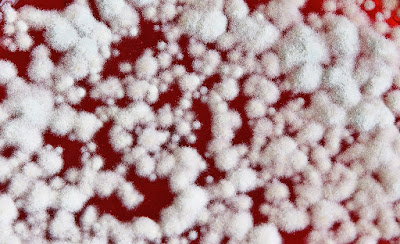

Antud lehel olevad pildid on autorikaitse all ning neid võib kasutada/levitada ainult autori otsesel nõusolekul. reikar1@gmail.com
All photos on this page are copyrighted by the photographer and may not be used without permission! Contact: reikar1@gmail.com
All photos on this page are copyrighted by the photographer and may not be used without permission! Contact: reikar1@gmail.com
pühapäev, 21. juuni 2009
Rallionu
Labels:
28-90mm,
canon 350d,
inimesed
laupäev, 20. juuni 2009
Juga
Labels:
canon 350d,
Eesti,
KIT-objektiiv,
suvi,
vesi
reede, 19. juuni 2009
Õnnetus nõndamoodi...
Labels:
canon 350d,
inimesed,
KIT-objektiiv,
suvi
teisipäev, 16. juuni 2009
Soditud.
Labels:
canon 350d,
ehitised,
KIT-objektiiv,
Tartu
UnIsTuS
Labels:
canon 350d,
KIT-objektiiv,
loodus,
maastik,
on the road,
suvi,
taevas
neljapäev, 4. juuni 2009
Ülesõit
Labels:
canon 350d,
KIT-objektiiv,
rong,
Tartu
kolmapäev, 3. juuni 2009
>Pehme<
Labels:
28-90mm,
canon 350d,
still-life,
Tartu
Tellimine:
Kommentaarid (Atom)